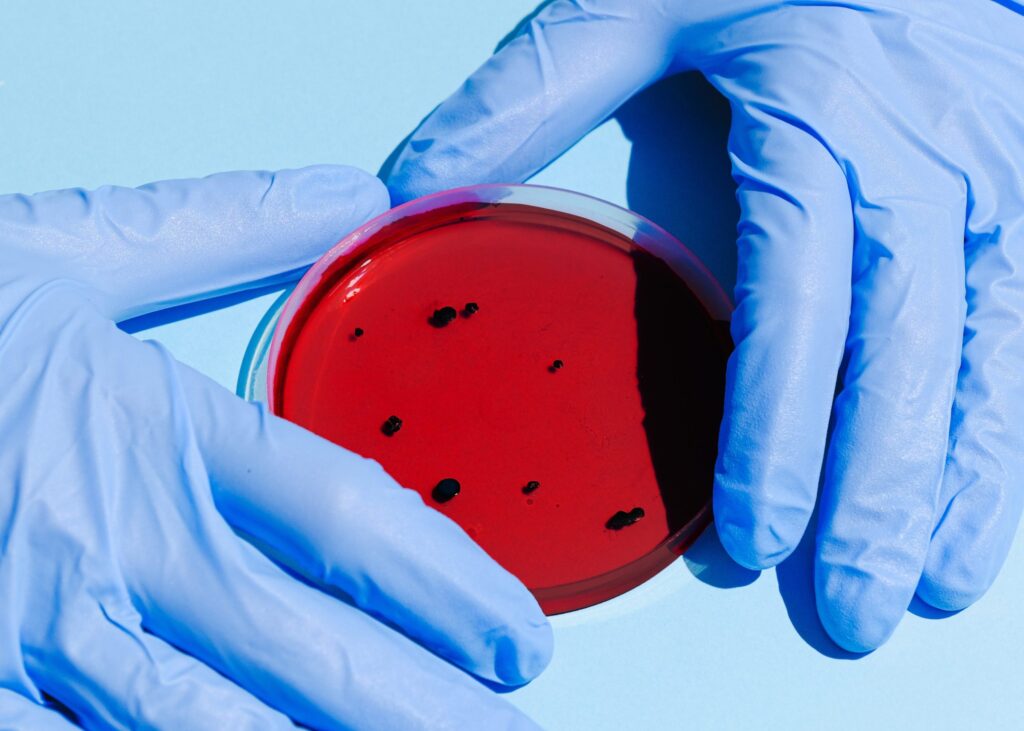

Si les premières études semblent indiquer que le taux de mortalité de la COVID-19 soit plus élevé chez les hommes que chez les femmes, les conséquences à long terme de la pandémie pourraient s’avérer bien plus lourdes pour ces dernières.
Surveillez l'arrivée de notre
APPLICATION MOBILE!
Disponible bientôt
Publicité

Articles populaires

- 10 avril 2026

- 8 avril 2026